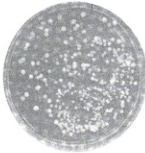

2025年新坐标同步练习高中生物选择性必修第三册人教版青海专版
注:目前有些书本章节名称可能整理的还不是很完善,但都是按照顺序排列的,请同学们按照顺序仔细查找。练习册 2025年新坐标同步练习高中生物选择性必修第三册人教版青海专版 答案主要是用来给同学们做完题方便对答案用的,请勿直接抄袭。
第14页
- 第1页
- 第2页
- 第3页
- 第4页
- 第5页
- 第6页
- 第7页
- 第8页
- 第9页
- 第10页
- 第11页
- 第12页
- 第13页
- 第14页
- 第15页
- 第16页
- 第17页
- 第18页
- 第19页
- 第20页
- 第21页
- 第22页
- 第23页
- 第24页
- 第25页
- 第26页
- 第27页
- 第28页
- 第29页
- 第30页
- 第31页
- 第32页
- 第33页
- 第34页
- 第35页
- 第36页
- 第37页
- 第38页
- 第39页
- 第40页
- 第41页
- 第42页
- 第43页
- 第44页
- 第45页
- 第46页
- 第47页
- 第48页
- 第49页
- 第50页
- 第51页
- 第52页
- 第53页
- 第54页
- 第55页
- 第56页
- 第57页
- 第58页
- 第59页
- 第60页
- 第61页
- 第62页
- 第63页
- 第64页
- 第65页
- 第66页
- 第67页
- 第68页
- 第69页
- 第70页
- 第71页
- 第72页
- 第73页
- 第74页
(1)筛选分解尿素的细菌的培养基以尿素为唯一氮源且为固体培养基。 (
(2)利用稀释涂布平板法统计菌落数目时,统计的菌落数就是活菌的实际数。 (
(3)统计菌落数目时为保证结果准确,一般选择菌落数目最多的平板进行统计。 (
(4)只有平板划线法能实现细菌的分离和计数。 (
(5)利用显微镜直接计数法统计的细菌数量就是活菌的数目。 (
(6)培养分解尿素的细菌,培养基的pH会增大。 (
√
)(2)利用稀释涂布平板法统计菌落数目时,统计的菌落数就是活菌的实际数。 (
×
)(3)统计菌落数目时为保证结果准确,一般选择菌落数目最多的平板进行统计。 (
×
)(4)只有平板划线法能实现细菌的分离和计数。 (
×
)(5)利用显微镜直接计数法统计的细菌数量就是活菌的数目。 (
×
)(6)培养分解尿素的细菌,培养基的pH会增大。 (
√
)
答案:
(1)√
(2)× 利用稀释涂布平板法统计菌落数目时,统计的菌落数要比活菌的实际数少。
(3)× 统计菌落数目时为保证结果准确,一般选择菌落数目在30~300的平板进行计数。
(4)× 平板划线法只能实现细菌的分离,不能进行计数。
(5)× 利用显微镜直接计数法统计的细菌数量要比活菌的数目多。
(6)√
(1)√
(2)× 利用稀释涂布平板法统计菌落数目时,统计的菌落数要比活菌的实际数少。
(3)× 统计菌落数目时为保证结果准确,一般选择菌落数目在30~300的平板进行计数。
(4)× 平板划线法只能实现细菌的分离,不能进行计数。
(5)× 利用显微镜直接计数法统计的细菌数量要比活菌的数目多。
(6)√
菌落总数可作为判定食品被污染程度的标志,也可以用于观察细菌在食品中繁殖的动态,以便对送检样品进行卫生学评估提供证据。如图是某样品培养简化流程图,请回答下列问题:

(1)对样品悬液怎样进行梯度稀释?
(2)涂布器一般是在酒精中浸泡,然后放在酒精灯火焰上灼烧灭菌,该操作的目的是什么?
(3)下图是涂布平板操作的示意图,用字母和箭头表示涂布平板操作的正确步骤:______。

(4)当菌液稀释倍数足够高时,培养基表面生长的一个单菌落来源于一个活菌。用稀释涂布平板法接种培养结果如右图所示。与平板划线法相比,为什么稀释涂布平板法可以用于细菌的计数?

(1)取1mL样品上清液加入盛有9mL无菌水的试管中,依次等比稀释。
(2)杀死涂布器上的微生物,防止杂菌污染。
(3)a→b→c→d
(4)稀释涂布平板法会进行等比稀释,在合适的稀释倍数下,均匀涂布得到的菌落互不接触,可以确定菌落的密度,再通过计算可以得知原菌液的细菌数量。

(1)对样品悬液怎样进行梯度稀释?
(2)涂布器一般是在酒精中浸泡,然后放在酒精灯火焰上灼烧灭菌,该操作的目的是什么?
(3)下图是涂布平板操作的示意图,用字母和箭头表示涂布平板操作的正确步骤:______。

(4)当菌液稀释倍数足够高时,培养基表面生长的一个单菌落来源于一个活菌。用稀释涂布平板法接种培养结果如右图所示。与平板划线法相比,为什么稀释涂布平板法可以用于细菌的计数?
(1)取1mL样品上清液加入盛有9mL无菌水的试管中,依次等比稀释。
(2)杀死涂布器上的微生物,防止杂菌污染。
(3)a→b→c→d
(4)稀释涂布平板法会进行等比稀释,在合适的稀释倍数下,均匀涂布得到的菌落互不接触,可以确定菌落的密度,再通过计算可以得知原菌液的细菌数量。
答案:
(1)取1mL样品上清液加入盛有9mL无菌水的试管中,依次等比稀释。
(2)杀死涂布器上的微生物,防止杂菌污染。
(3)a→b→c→d
(4)稀释涂布平板法会进行等比稀释,在合适的稀释倍数下,均匀涂布得到的菌落互不接触,可以确定菌落的密度,再通过计算可以得知原菌液的细菌数量。
(1)取1mL样品上清液加入盛有9mL无菌水的试管中,依次等比稀释。
(2)杀死涂布器上的微生物,防止杂菌污染。
(3)a→b→c→d
(4)稀释涂布平板法会进行等比稀释,在合适的稀释倍数下,均匀涂布得到的菌落互不接触,可以确定菌落的密度,再通过计算可以得知原菌液的细菌数量。
查看更多完整答案,请扫码查看


